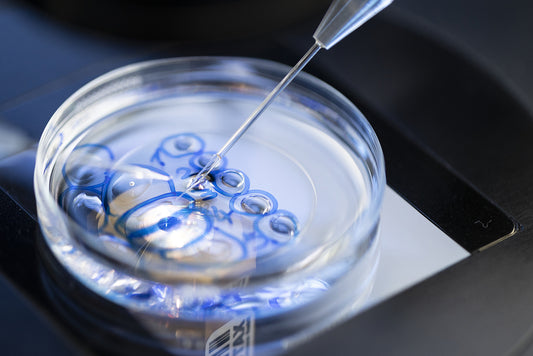
ICSI-Intrazytoplasmatische Spermieninjektion
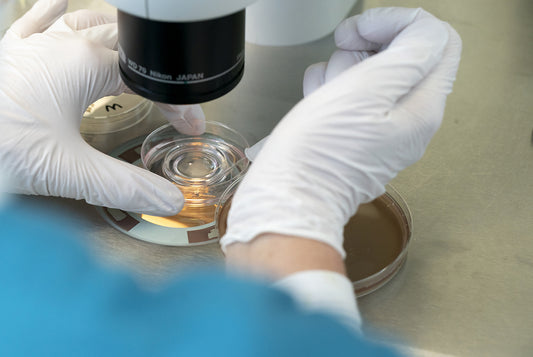
IVF-In vitro Fertilisation

Ursachen für einen unerfüllten Kinderwunsch

Tritt trotz regelmäßigen Geschlechtsverkehrs innerhalb von einem Jahr keine Schwangerschaft ein, so sollte nach möglichen Ursachen geforscht werden. Bei Frauen über 35 Jahren sollte weniger lange abgewartet werden.
Ursachen bei der Frau: ca. 30%
- Hormonelle Störungen und ungenügende Eizellreifung
- Funktionseinschränkung der Eileiter
- Fehlbildungen von Eierstöcken, Eileitern oder der Gebärmutter
- Endometriose: Gebärmutterschleimhaut, die außerhalb der Gebärmutter wächst, zum Beispiel im Eileiter, im Eierstock oder in der Harnblase / Darm
- Genetische Ursachen
Ursachen beim Mann: ca. 30%
- Eingeschränkte Qualität/Fehlen der Samenzellen
- Verschluss der ableitenden Samenwege, z.B. nach Infektionen, nach Sterilisation oder angeborene Fehlentwicklung der Samenleiter
- Genetische Ursachen
- Schwierigkeiten beim Geschlechtsverkehr
Ursachen bei beiden Partnern: ca. 30%
Keine nachweisbare organische Ursache: ca. 10%
Therapien
-
Blastozystenkultur
Normaler Preis €0,00Normaler PreisGrundpreis proVerkaufspreis €0,00 -
Einfrieren von befruchteten Eizellen oder Spermien (Kryokonservierung)
Normaler Preis €0,00Normaler PreisGrundpreis proVerkaufspreis €0,00 -
Fertilitätserhalt bei Chemo- und Strahlentherapie
Normaler Preis €0,00Normaler PreisGrundpreis proVerkaufspreis €0,00 -
Hilfe bei der Implantation (Einnistungsstörung)
Normaler Preis €0,00Normaler PreisGrundpreis proVerkaufspreis €0,00 -
Hodenbiopsie (TESE)
Normaler Preis €0,00Normaler PreisGrundpreis proVerkaufspreis €0,00 -
Hormonelle Stimulation
Normaler Preis €0,00Normaler PreisGrundpreis proVerkaufspreis €0,00 -
ICSI-Intrazytoplasmatische Spermieninjektion
Normaler Preis €0,00Normaler PreisGrundpreis proVerkaufspreis €0,00 -
Insemination
Normaler Preis €0,00Normaler PreisGrundpreis proVerkaufspreis €0,00 -
IVF Naturelle
Normaler Preis €0,00Normaler PreisGrundpreis proVerkaufspreis €0,00 -
IVF-In vitro Fertilisation
Normaler Preis €0,00Normaler PreisGrundpreis proVerkaufspreis €0,00 -
Klassische IVF/ICSI-Behandlung
Normaler Preis €0,00Normaler PreisGrundpreis proVerkaufspreis €0,00 -
Präimplantationsdiagnostik (PID)
Normaler Preis €0,00Normaler PreisGrundpreis proVerkaufspreis €0,00 -
Vitrifikation
Normaler Preis €0,00Normaler PreisGrundpreis proVerkaufspreis €0,00